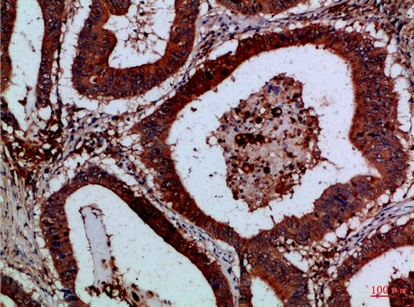
Fig.1. Immunohistochemical analysis of paraffin-embedded Human-colon-cancer, antibody was diluted at 1:100.

| Product name | Cystatin B Polyclonal Antibody |
| Immunogen | Synthesized peptide derived from part region of human Cystatin B protein at amino acid sequence of 20-60 |
| Host | Rabbit |
| Reactivity | Human,Rat,Mouse, |
| Applications | IHC,IF,ELISA |
| Applications notes | Optimal working dilutions should be determined experimentally by the investigator. Suggested starting dilutions are as follows: IHC 1:50-200;ELISA 1:10000-20000;IF 1:50-200 |
| Clonality | Polyclonal |
| Preparation method | The antibody was affinity-purified from rabbit antiserum by affinity-chromatography using epitope-specific immunogen. |
| Alternative | Cystatin-B; CPI-B; Liver thiol proteinase inhibitor; Stefin-B |
| Formulation | Liquid solution |
| Concentration | 1 mg/ml |
| Storage buffer | Liquid in PBS containing 50% glycerol, 0.5% BSA and 0.02% sodium azide. |
| Storage instructions | Stable for one year at -20°C from date of shipment. For maximum recovery of product, centrifuge the original vial after thawing and prior to removing the cap. Aliquot to avoid repeated freezing and thawing. |
| Shipping | Gel pack with blue ice. |
| Precautions | The product listed herein is for research use only and is not intended for use in human or clinical diagnosis. Suggested applications of our products are not recommendations to use our products in violation of any patent or as a license. We cannot be responsible for patent infringements or other violations that may occur with the use of this product. |
| Background | The cystatin superfamily encompasses proteins that contain multiple cystatin-like sequences. Some of the members are active cysteine protease inhibitors, while others have lost or perhaps never acquired this inhibitory activity. There are three inhibitory families in the superfamily, including the type 1 cystatins (stefins), type 2 cystatins and kininogens. This gene encodes a stefin that functions as an intracellular thiol protease inhibitor. The protein is able to form a dimer stabilized by noncovalent forces, inhibiting papain and cathepsins l, h and b. The protein is thought to play a role in protecting against the proteases leaking from lysosomes. Evidence indicates that mutations in this gene are responsible for the primary defects in patients with progressive myoclonic epilepsy (EPM1). One type of mutation responsible for EPM1 is the expansion in the promoter region of this gene of a CCCCGCCCCGCG repeat from 2-3 copies to 30-78 copies. |
| Gene ID | 1476 |
| Alternative | Cystatin-B; CPI-B; Liver thiol proteinase inhibitor; Stefin-B |
| Others | The antibody detects endogenous levels of Cystatin B |
| Accession | P04080 |
Fig.1. Immunohistochemical analysis of paraffin-embedded Human-colon-cancer, antibody was diluted at 1:100.

Fig.2. Immunohistochemical analysis of paraffin-embedded Human-colon-cancer, antibody was diluted at 1:100.

Fig.3. Immunohistochemical analysis of paraffin-embedded Human-placenta, antibody was diluted at 1:100.
You must be logged in to post a review.
Reviews
There are no reviews yet.